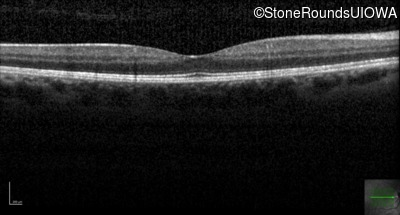
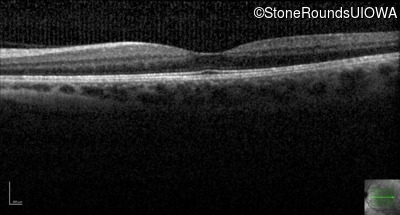

Case
SR86
Student Mode
AD CSNB (IA2fii)
Female
Female
Hidden
SR86
Student Mode
AD CSNB (IA2fii)
Female
Female
History
This 44 year old woman has had very poor vision in dim light for her entire life. She vividly remembers running into a picnic table on a bicycle in a campground as a child.